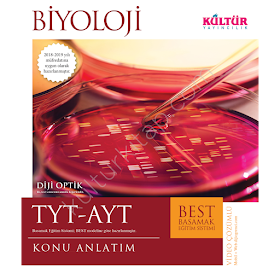
Kültür TYT AYT Best Biyoloji Konu Anlatımı PDF

- TYT KİTAPLARI
- _TYT Matematik PDF
- _TYT Türkçe PDF
- _TYT Coğrafya PDF
- _TYT Tarih PDF
- _TYT Felsefe PDF
- _TYT Din Kültürü PDF
- _TYT Fizik PDF
- _TYT Kimya PDF
- _TYT-AYT Biyoloji PDF
- _TYT-AYT Geometri PDF
- AYT KİTAPLARI
- _AYT Matematik PDF
- _AYT Edebiyat PDF
- _AYT Coğrafya PDF
- _AYT Tarih PDF
- _AYT Felsefe PDF
- _AYT Din Kültürü PDF
- _AYT Fizik PDF
- _AYT Kimya PDF
- _TYT-AYT Biyoloji PDF
- _TYT-AYT Geometri PDF
- SINIF KİTAPLARI
- _9. SINIF KİTAPLARI
- _10. SINIF KİTAPLARI
- _11. SINIF KİTAPLARI
- _12. SINIF KİTAPLARI
- DENEME KİTAPLARI
- _TYT DENEME ARŞİVİ
- _AYT DENEME ARŞİVİ
- TELİF HAKKI
YAYINLARA GÖRE KİTAPLAR
- 345 Yayınları PDF indir (10)
- A Yayınları PDF indir (14)
- Akıllı adam yayınları pdf indir (1)
- Altın Karma Yayınları PDF indir (2)
- Ankara Yayıncılık PDF indir (2)
- Antrenman Yayınları PDF indir (9)
- Arı Yayınları PDF indir (2)
- Ata Yayınları PDF indir (1)
- Aydın yayınları pdf indir (11)
- Açı Yayınları PDF indir (1)
- Başarıyorum Yayınları PDF indir (5)
- Bilfen Yayınları PDF indir (10)
- Bilgi Sarmalı PDF indir (21)
- Bilim Lisesi Denemeleri PDF (2)
- Binot yayınları pdf indir (17)
- Derece Yayınları PDF (5)
- Duru Yayınları Fena Matematik PDF indir (1)
- Edge Akademi PDF indir (1)
- Editör Yayınları PDF indir (4)
- Editör seçimi (8)
- Eksen Yayınları PDF indir (6)
- Ekstrem Yayınları PDF indir (17)
- Ekstremum Yayınları PDF indir (9)
- Endemik Yayınları PDF indir (43)
- Esen Yayınları PDF indir (32)
- FDD Yayınları PDF indir (28)
- Fem Yayınları PDF indir (42)
- Fen Bilimleri PDF indir (7)
- Fencebir Yayınları PDF (1)
- Fides Yayınları PDF indir (1)
- Final Yayınları PDF indir (14)
- Gezegen Yayınları PDF indir (4)
- Gür Yayınları PDF indir (93)
- Hız Yayınları PDF indir (1)
- Hız ve Renk PDF indir (6)
- Kafa Dengi PDF indir (2)
- Karekök Yayınları PDF indir (84)
- Kida Yayınları PDF indir (10)
- Köşegen Yayınları PDF indir (25)
- Lider Plus PDF indir (2)
- Matematik Kulübü PDF indir (6)
- Matematik Vadisi PDF (3)
- Matematiğin Kara Kutusu PDF indir (2)
- Meb Kitapları PDF indir (5)
- Merkez yayınları pdf indir (2)
- Metin Yayınları PDF indir (16)
- Mikro Hücre Yayınları PDF indir (15)
- Muba yayınları pdf indir (5)
- Nego Yayınları PDF indir (1)
- Nihat Bilgin Yayınları PDF indir (2)
- Nitelik Yayınları PDF indir (2)
- PRF Yayınları PDF indir (4)
- Palme Yayınları PDF indir (41)
- Pandül yayınları PDF indir (13)
- Paraf Yayınları PDF indir (10)
- Paragrafın Şifresi PDF indir (4)
- Plazma Yayınları PDF indir (1)
- Sadık uygun yayınları pdf indir (4)
- Seviye Yayınları PDF (2)
- Sonuç Yayınları PDF indir (69)
- Soru Kalesi PDF indir (18)
- Supara Yayınları PDF indir (14)
- Sıradışı Analiz Yayınları PDF (1)
- Tammat Yayınları PDF indir (4)
- Teas press yayınları pdf indir (16)
- Test Okul Yayınları PDF indir (4)
- Tonguç Yayınları PDF (5)
- Töder Yayınları PDF (3)
- Tümay yayınları pdf indir (17)
- Uygar yayınları PDF indir (1)
- YKS Deneme Arşivi (37)
- Yanıt Yayınları PDF indir (8)
- Yayın Denizi PDF indir (71)
- Yüzde Yüz Yayınları PDF indir (7)
- Yıldız Serisi Yayınları PDF (10)
- Çap Yayınları PDF indir (89)
- Çağrışım Yayınları PDF indir (2)
- Özdebir Yayınları PDF indir (4)
- İsabet Yayınları PDF indir (5)
- İsem Yayınları PDF indir (1)
- İşleyen Zeka PDF indir (13)
Telif Hakkı
Sitemizde paylaşılan kitaplar çeşitli sitelerden toplanıp kitabı almadan önce incelenmesi yani tanıtım amacıyla paylaşılmaktadır. Her türlü konuda aşağıdaki mail adresine yazabilirsiniz.
abuse.spi@yandex.com
link
Created By SoraTemplates | Distributed By Blogger Templates